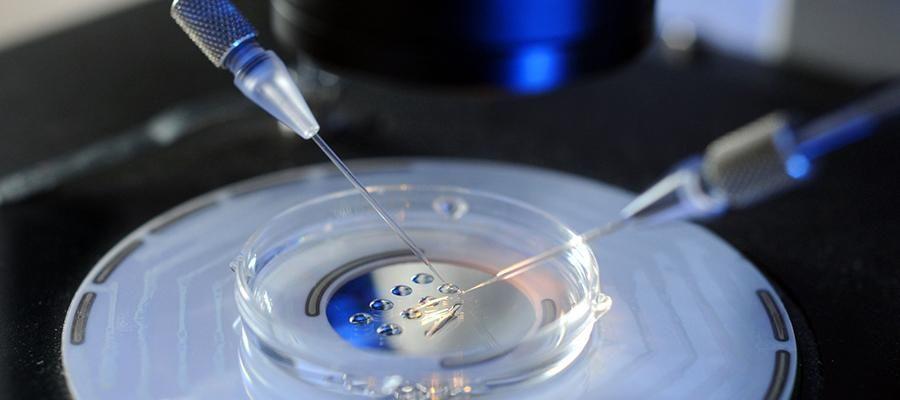
试管婴儿成功率多少？移植一颗胚胎80%怀孕成功率

-

佛学哲理 人的一颗心能在瞬间产生千万种变化
从前的古寺之中有一个小沙弥,都说他的慧根极佳,倘若能够好好的照顾未来一定是一个有用之才。而小沙弥确实也不负众望,从小便是优秀的哪一个,无论是佛法的研修亦或是佛学..
2023-04-05 22:49 -

公立医院一颗卵子的价格大概是多少?
公立医院一颗卵子的价格大概是多少?供卵虽然在中国是合法的,但是做起来是有条件的。公立医院提供一个卵子of费用,大概是1-2万元。目前试管婴儿是一项成熟的技术,在临床..
2023-04-30 10:48 -

国内正规医院卵子库卵子多少钱?一颗费用五万够不够?
国内正规医院卵子库卵子多少钱?一颗费用五万够不够?医生说我卵巢早衰特别严重,生孩子没希望了。只有用别人的卵子做试管,我才有希望怀孕。我很想有一个自己的孩子。想咨..
2023-05-16 11:45 -

山东省立医院做供精人工授精买一颗精子要花多少钱?
今年30岁,结婚两年,一直没有要孩子,今年和老婆开始有备孕的打算,想要个孩子,但是去医院检查发现自己有死精症,治疗了大概45个月,也没有什么明显效果。医生说可以去尝..
2023-05-16 12:23 -

吃了避孕药是不是就可以射里面了(一颗紧急避孕药的内心独白)
我是丹媚一颗紧急避孕药在这个谈性色变但又敢做敢爱的时代人们会逃避我,但也很需要我今天,我要为自己正名来一次正经科普 紧急避孕药,顾名思义,我一生的使命就是避孕。..
2023-06-20 07:05 -

长沙中信湘雅做供卵试管一颗卵子费用大概多少钱?5万够吗?
长沙中信湘雅做供卵试管一颗卵子费用大概多少钱?5万够吗?长沙中信湘雅排队等卵试管卵子没钱,因为我们国家的卵试管卵的来源来自于其他做试管周期的女性的免费捐赠。我国..
2023-10-18 17:19 -

向卵子库借卵生子时女性的一颗卵子值多少钱?
向卵子库借卵生子时女性的一颗卵子值多少钱?我目前年龄大了已经绝经,无法正常排卵,但是我又很想生个儿子,所以想做试管,听说可以用别人的卵子跟自己老公的精子做试管生..
2024-03-21 09:20 -

长沙中信湘雅做供卵第三代试管婴儿一颗卵子费用大概多少钱?5万够吗?
长沙中信湘雅做供卵第三代试管婴儿一颗卵子费用大概多少钱?5万够吗?长沙中信湘雅排队等卵试管婴儿卵子没钱,因为我们国家的卵试管婴儿卵的来源来自于其他做供卵第三代试..
2024-04-27 09:24 -

精子库一颗精子多少钱,购买精子费用明细!
精子库一颗精子多少钱,购买精子费用明细!生活中,很多育龄夫妇都有生育困难。虽然其中大部分是由于女性身体原因导致的不育症,但男性不育症也不容忽视,如少精症和无精症..
2024-07-11 09:41 -

amh0.62能自然怀孕吗?只剩一颗卵子也不能放弃希望
AMH检查可评价卵巢储备功能,得知卵巢中卵子数量,估算女性的生殖能力及更年期时间。amh值会随着卵巢功能的变化呈起伏变化。如果女性卵巢中的卵泡的数目比较多,这时amh的..
2024-07-13 10:10 -

国内做试管婴儿有哪些医院可以买卵子呢?现在买卵子多少钱一颗
国内做试管婴儿有哪些医院可以买卵子呢?现在买卵子多少钱一颗?由于自身无法提试管婴儿子的女性朋友,而没有卵子想要实现生育必然只能通过试管婴儿的途径来实现。那么国内..
2024-07-15 10:09 -
去正规医院卵子库购买一颗卵子大概要多少钱?
去正规医院卵子库购买一颗卵子大概要多少钱?一个卵子大概要1-2万,在正规医院买一个卵子大概要1-2万。当然,因为每个医院的收费标准和档次不一样,费用也不一样。现在这种..
2024-07-29 09:26 -
试管婴儿成功率多少?移植一颗胚胎80%怀孕成功率
「试管婴儿成功率80%」给您的直觉是什么? 高档精品打八折会让您心动吗? 考试或评量落在80%以上是A咖,好感度(NPS)8分以上值得感动推荐,假如试管做人植一颗胚胎高达80%..
2024-09-12 09:11 -

amh值0.45做试管有希望吗?做母亲只需要一颗好的卵子!
amh值0.45做试管有希望吗?其实amh值过低的情况下,无论是自然怀孕还是做试管婴儿都是比较困难的。对于这类女性,要做的就是及时进行治疗,不要花过多的时间再自然怀孕上面..
2024-10-04 09:36 -

amh0.52还有机会生育吗?一颗卵也能绝处逢生
amh是检测卵巢功能最主要的指标,amh又称抗缪勒管激素,是由卵巢小卵泡所分泌的激素,如果卵巢内小卵泡越多,测得的amh数值就越高,如果卵巢内的小卵泡越少,测得的数值就..
2024-10-12 09:52 -

一颗卵子的自述:我最害怕这6件事-爱我就别伤害我
导读:我们卵子可是奢侈的消耗品,是不可再生的!别看你出生就随身携带了上百万的卵泡,但到了你13、14岁的时候,开始排卵了,我们已经只剩下30万,在这期间,我们很多小姐..
2024-11-01 09:51 -

amh值0.25还有做试管的希望吗?做试管只需要一颗高质量的卵子即可
最近小编看到了很多在提问“amh值0.25还有做试管的希望吗”,提起amh值大家并不会陌生,在做试管婴儿前都会检测amh值以此来判断卵巢的储备功能。amh值越高,卵子储备能力越..
2024-11-06 10:53 -

42岁amh只有0.01还能做试管吗?一颗卵也能成功逆袭
42岁amh只有0.01还能做试管吗?对于高龄女性来说,生育能力的流逝让很多还有生育需求的女性深感无力。而amh的降低同样也预示着卵巢功能的衰退,这种衰退同样没有任何有效手..
2024-11-09 09:24 -

一颗卵子的西天取“精”记
每一个新生命诞生,都是卵子和精子爱的结合。大家可能都听说过,2亿精子中最终只有一颗能打动卵子,与卵子结合,而剩下其他的精子都会被淘汰。但大家可能不知道,其实卵子..
2024-12-12 09:17 -

全为不动精子做试管婴儿能成功吗?一颗种子就可以孕育一个生命
近年来,不孕不育家庭数量不断在上升,其中男女不孕不育因素各占50%。而试管婴儿技术的出现解决了许许多多家庭的生儿育女梦想,尤其是第二代试管婴儿技术的出现,解决的主..
2024-12-19 10:00
微信分享
扫描二维码分享到微信或朋友圈